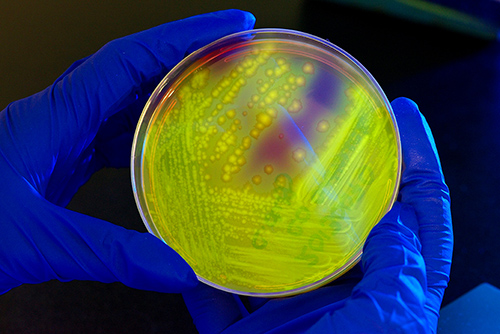

You are here
Antibiotic Stewardship: Improving Prescribing and Use
The U.S. Centers for Disease Control and Prevention (CDC) estimates that each year in the United States more than 2 million people are infected with antibiotic-resistant organisms, resulting in approximately 23,000 deaths. Antibiotics are critical, life-saving tools that have revolutionized medical care, but misuse of these drugs is reducing their effectiveness. This week marks the annual Get Smart About Antibiotics Week, which is an observance raising awareness of the threat of antibiotic resistance and the importance of appropriate antibiotic prescribing and use.
Doctors and other health professionals around the world are increasingly adopting principles of responsible antibiotic use, often called antibiotic stewardship. Stewardship is a commitment to use antibiotics only when they are necessary to treat, and, in some cases, prevent disease; to choose the right antibiotics; and to administer them in the right way in every case. Efforts to improve the responsible use of antibiotics have not only demonstrated these benefits but have also been shown to improve outcomes and save healthcare facilities money in pharmacy costs.
The CDC Foundation announced a new partnership today with The Pew Charitable Trusts to analyze antibiotic use in inpatient and outpatient healthcare settings in the United States. Pew’s commitment includes continued collaboration with CDC to provide both clinicians, public health officials and policymakers with the data and tools necessary to improve how antibiotics are prescribed and used. A better understanding of how antibiotics are used inside and outside of hospitals will help us identify where improvements in prescribing practices are needed to protect patients and provide high-quality health care. This investment will help CDC do more rapid analyses of our data and set the course to improve antibiotic use in the United States to preserve the effectiveness of antibiotics for generations to come.